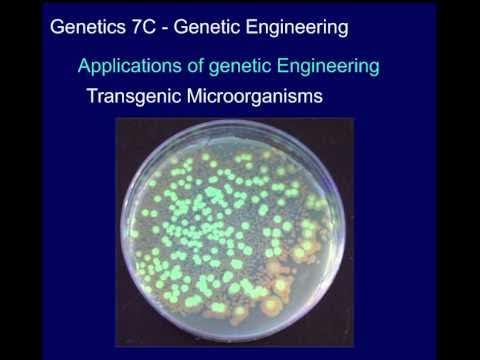

Experience the pulse of yuan 2016 | pdf | genetic algorithm | data mining with our extensive urban gallery of hundreds of images. featuring energetic examples of photography, images, and pictures. designed to showcase urban culture and lifestyle. Discover high-resolution yuan 2016 | pdf | genetic algorithm | data mining images optimized for various applications. Suitable for various applications including web design, social media, personal projects, and digital content creation All yuan 2016 | pdf | genetic algorithm | data mining images are available in high resolution with professional-grade quality, optimized for both digital and print applications, and include comprehensive metadata for easy organization and usage. Our yuan 2016 | pdf | genetic algorithm | data mining gallery offers diverse visual resources to bring your ideas to life. Diverse style options within the yuan 2016 | pdf | genetic algorithm | data mining collection suit various aesthetic preferences. Multiple resolution options ensure optimal performance across different platforms and applications. Whether for commercial projects or personal use, our yuan 2016 | pdf | genetic algorithm | data mining collection delivers consistent excellence. Professional licensing options accommodate both commercial and educational usage requirements. The yuan 2016 | pdf | genetic algorithm | data mining collection represents years of careful curation and professional standards. Each image in our yuan 2016 | pdf | genetic algorithm | data mining gallery undergoes rigorous quality assessment before inclusion.

![[보고서]율무 유전체 해독 및 고밀도 유전지도 구축](https://nrms.kisti.re.kr/bitextimages/TRKO202200009147/TRKO202200009147_30_image_1.png)












































![[LOOSE CUT] 2.5mm x 2C /3C /4C /7C /12C Armoured Cable / Underground ...](https://www.superlighting.com.my/image/superlighting/image/data/all_product_images/product-761/5pISBtMR1727319845.jpg)



























